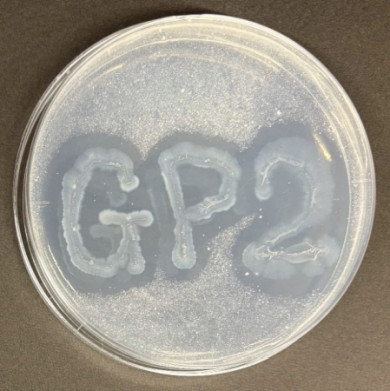

生分解性プラスチックを高速分解する微生物を発見:研究開発の最前線
慶應義塾大学は、カネカが製造する生分解性プラスチック「Green Planet(GP)」を、数日で完全に分解する微生物を発見した。フィルムは3日、ストローは約2週間で完全分解した。
» 2025年03月07日 11時00分 公開
[MONOist]
慶應義塾大学は2025年2月26日、カネカが製造する生分解性プラスチック「Green Planet(GP)」を、数日で完全に分解する微生物を発見したと発表した。GPを使用した店舗などでのオンサイト分解処理につながることが期待される。
今回の研究では、カネカ高砂工業所(兵庫県高砂市)内のGP生産プラント近辺の環境サンプルから、GPの分解菌を探索。GPパウダーを含む寒天プレートに塗布したところ、いくつかの候補株のコロニー周辺に透明な領域(ハロー)を確認した。
ハローを作った微生物は、GPを分解する酵素を細胞の外側に排出していると思われる。GPフィルムを用いてこれらの候補株を評価すると、Acidovorax属の微生物となるGP-2株が最大の分解率を示した。GP-2株は3日で分解率が約100%となり、フィルムより厚いストローは約2週間で完全分解した。
カネカのGPは、他の生分解性プラスチックに比べて高い生分解性を示すが、環境中での分解には数週間〜数カ月程度を要する。GP-2株による分解率は、従来とは段違いに高速な処理時間となる。今後、さらなる解析や条件の最適化を図り、実装化を目指す。
関連記事
 ファミマが生分解性バイオポリマーを使用したスプーンとフォークを発売
ファミマが生分解性バイオポリマーを使用したスプーンとフォークを発売
カネカのバイオポリマー「Green Planet」を使用したスプーンとフォークが、ファミリーマートの地球環境問題に対する取り組み「コンビニエンスウェア ブルーグリーン」プロジェクトで商品化された。 カネカがAIシステムで樹脂プラントの乾燥設備を最適運転、年間100t増産
カネカがAIシステムで樹脂プラントの乾燥設備を最適運転、年間100t増産
本稿ではカネカが独自開発したAIシステムで樹脂プラントの連続乾燥設備の最適な運転を実現し、年間100tの増産を達成した事例などを紹介する。 カネカが小学生向け環境教育プログラムを制作、生分解性バイオポリマーで意識醸成
カネカが小学生向け環境教育プログラムを制作、生分解性バイオポリマーで意識醸成
カネカはARROWSと共同で、小学5〜6年生を対象に環境教育プログラムを制作し、希望する小学校に提供を開始した。生分解性バイオポリマー「Green Planet」を教材として活用し、児童に環境問題に対する意識を醸成する狙いだ。 カネカと大成建設が太陽電池を用いた外装発電システムの販売会社を設立
カネカと大成建設が太陽電池を用いた外装発電システムの販売会社を設立
カネカと大成建設は、共同開発した太陽電池モジュールで発電する外装発電システム「Green Multi Solar」を販売する目的でG.G.Energyを設立し、2024年4月から本格的に営業を開始したと発表した。 製造業のAI活用をよりポップに、クリック操作でデータ分析が行えるプラットフォーム
製造業のAI活用をよりポップに、クリック操作でデータ分析が行えるプラットフォーム
企業によるデータ活用のためのAI(人工知能)プラットフォームを提供するDataiku Japanは2023年9月5日、同社のサービスや経営戦略に関する説明会をオンラインで開催した。
関連リンク
Copyright © ITmedia, Inc. All Rights Reserved.
Special ContentsPR
特別協賛PR
スポンサーからのお知らせPR
Special ContentsPR
Pickup ContentsPR
素材/化学の記事ランキング
- ガラスや有機の限界を超える! 次世代セラミック基板を初披露
- 次世代半導体向けガラスコア基板の課題打破、TGV深穴加工に成功
- 生成AIブームを支える材料、JX金属が生産能力増強を決定
- レゾナックが生成AI向け半導体封止材の特許維持、異議申し立てを論破
- 失敗データも資産に! 研究現場を変える無料のノートアプリ
- 半導体やフォルダブルスマホに照準、日東電工が描く次世代の成長戦略
- 廃棄エアコンからレアアース磁石を回収、国内使用量の35%を賄う
- 今夏も危険な暑さ――命を守る「難燃×冷感インナー」造船現場向けクラボウら開発
- 最薄板厚30μm、宇宙用超薄板カバーガラスの新ブランド
- トクヤマが台湾で半導体用高純度IPAの第2プラント建設、生産能力は……
Special SitePR
コーナーリンク
あなたにおすすめの記事PR
GPパウダーを含む寒天プレートにGP-2株を塗布した様子。GPパウダーが分解されて透明な領域が確認できる 出所:慶應義塾大学
GPパウダーを含む寒天プレートにGP-2株を塗布した様子。GPパウダーが分解されて透明な領域が確認できる 出所:慶應義塾大学




